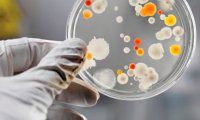
Вирус Коксаки готов к переезду в Россию

Новый реактивный самолет России превосходит по скорости F-22 Raptor
Россия объявила о том, что ее Военно-воздушные силы скоро получат первую партию долгожданных сверхзвуковых боевых реактивных самолетов. Их скорость будет выше, чем у американских истребителей F-22,...